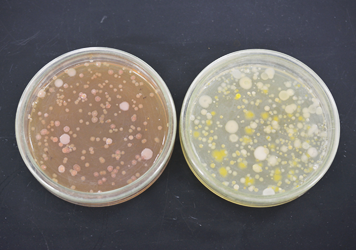
(左)大腸菌群数(右)一般生菌数イメージ
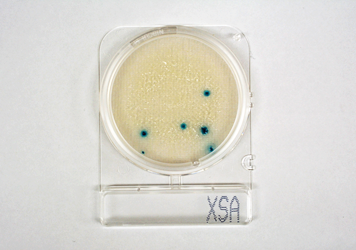
フィルム培地による細菌検査イメージ

毎年全国で発生する集団食中毒は実に1,000件以上と言われていますが、細菌を原因とするものが半数以上を占め(55~60%)、その次にノロウイルスなどのウイルスを原因とするものと続きます。いずれにしても食中毒は食品を扱う企業にとっては大きな脅威となっています。一方、「食の安全性」をもとめる消費者の増加によって、企業としては取扱食品や加工製品に対する品質管理やトレーサビリティ管理など、これまで以上に厳しい対応が求められています。
安全な食と食環境のために、予防的衛生管理のための検査・調査受託とともに、組成基準分析やうま味成分分析、品種同定などを通して、食品の高付加価値化をサポートします。
食品加工企業、食品流通企業、食品関連研究施設
ホテル、レストラン、食堂、ファストフードなど外食系料飲店、産業給食企業など
農業・漁業・酪農関連施設など
食品衛生法で定められた製品の規格検査、製品や原材料の汚染度を評価するための衛生指標菌検査(一般生菌数・大腸菌群数等)、食中毒の原因菌検査(黄色ブドウ球菌等)を行っています。その他に賞味期限を設定するための保存試験やレストラン厨房や食品加工工場などでの拭き取り検査やスタンプ検査(一般生菌数・大腸菌群数・黄色ブドウ球菌等)も行っています。

食品微生物検査
(左)大腸菌群数、(右)一般生菌数
レストラン厨房や食品加工工場内の設備・器具・調理従業者の手指等に対して、拭き取り検査やスタンプ検査(一般生菌数・大腸菌群・黄色ブドウ球菌等)を行うことにより洗浄度や汚染度を評価します。同時に飲料水の水質検査も可能です。
フィルム培地による黄色ブドウ球菌検査
厨房など、施設の衛生状態や作業環境などを点検・チェックし、アドバイスを含めたレポート(報告書)を提出する他、必要に応じて衛生管理マニュアルを作成。環境にあわせた衛生管理システム構築をサポートします。
食品の加工前と加工後のサンプルをあわせて分析し、生産過程での人為的添加等がないことを示すことによって、品質管理証明とトレーサビリティ証明に大きな価値を生み出します。弊社では、特にハチミツと乳製品についての実績が豊富です。

ハチミツの組成分析
栄養表示項目、ミネラル類等の栄養成分分析や金属分析、残留農薬分析、異物検査等ニーズに応じて様々な検査を行っています。また、近年注目を集めている「うまみ成分」の分析(遊離アミノ酸、核酸、ペプチド構成アミノ酸総量、糖類等)や官能試験、テクスチャー試験などの美味しさの評価や次々と新しい種が生み出されている農産物の品種同定も行っています。

高速液体クロマトグラフィによる糖類分析

原子吸光光度計による金属分析






